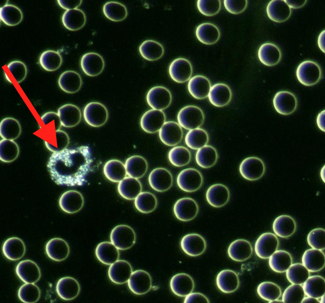

- Friskvård hela Sverige
c/o health
FRIDHEMSPLAN 2B, 792 30 Mora
4.7

Alla tjänster
FUNKTIONSMEDICINSK KONSULTATION
2
NYBESÖK Funktionsmedicinsk konsultation med provtagning
120 min
En funktionsmedicinsk konsultation (nybesök) tar två timmar och går till så här:
1. Du får en enkät på din mail, som du fyller i och skickar tillbaka. Denna har vi sedan som underlag för ditt nybesök.
2. Du kommer till kliniken och vi går igenom din hälsohistoria grundligt. Här tar vi reda på all information vi behöver, för en så komplett analys (anamnes) som möjligt.
3. Blodanalys med levande och torkat blod. Urinprov och Hb-test.
4. Vi utformar en handlingsplan med näringsråd samt ev. vidare åtgärder som remiss till ytterligare provtagning eller annan terapeutisk behandling.
Under blodanalysen tittar vi tillsammans på en liten droppe av ditt blod i mikroskop direkt på plats och du kan samtidigt följa med på en skärm.
Dessa tendenser kan vi se i blodet:
Hur aktivt immunförsvaret är.
Tecken på inflammation i kroppen.
Hur du påverkas av stress.
Brist på B12, folsyra och järn.
Matsmältningsproblem.
Belastad lever och / eller njurar.
Blodcirkulationsproblem.
Läckande tarm.
Candida (svamp) och bakterier.
Vårt blod har kontakt med nästan varenda cell i hela kroppen. Dess betydelse är livsavgörande för vår överlevnad, och att det fungerar felfritt är grundläggande för vårt välbefinnande. Blodets funktion är bl.a. att transportera syre, dvs hjälpa kroppen att andas. Men också att transportera näringsämnen och föra bort avfallsprodukter, samt bekämpa infektioner.
Konsultationen utförs av Maria Troive Lindell, diplomerad Hälsopedagog, Kost- och näringsterapeut samt motivationscoach.
Pris1 890 kr
Funktionsmedicinsk konsultation återbesök 60 min
60 min
Denna tjänst kan endast bokas av dig som varit på ett nybesök hos oss.
Vid ett återbesök gör vi samma tester som vid första besöket. Vi går igenom vad som förändrats och beslutar därefter hur du ska gå vidare.
Pris890 kr
HÄLSOCOACHING
5
Coaching / samtalsterapi
60 min
Motiverande samtal för dig som vill öka din hälsa och välmående i ditt liv. En livsstilsförändring helt enkelt.
Tillsammans tittar vi på hur du lever idag, och vad det är som du skulle vilja förändra.
Du väljer fokus, men ämnen som vi ofta berör är stress, mat, sömn, rörelse, tankar och beteenden. Dvs allt det som gör en mer eller mindre frisk och glad.
Utifrån dina behov så skapar vi en realistisk plan för hur du ska komma vidare och mot målet.
Vi delar gärna med oss av recept, meditationer, övningar, smarta lösningar och lifehacks, vill du ha någon sorts schema så kan vi göra det. Däremot så jobbar vi inte med kalorirestriktioner eller specifika dieter.
VI rekommenderar 3-5 samtal, men det går självklart bra att bara göra ett samtal (eller jättemånga fler).
Vi arbetar utifrån ett salutogent förhållningssätt och använder oss av MI metoden (motivation interviewing), vilket båda är erkända och evidensbaserade metoder med fina resultat.
Vårt mål är att du ska hitta ditt sätta att göra en förändring så att du kan leva det liv du vill leva!
Om du har mer frågor så hör gärna av dig till oss! Info@cohealth.se
Pris890 kr
Hälsocoaching
60 min
Hälsocoaching
En serie motiverande samtal för dig som vill öka din hälsa och välmående i ditt liv. En livsstilsförändring helt enkelt.
Tillsammans tittar vi på hur du lever idag, och vad det är som du skulle vilja förändra.
Du väljer fokus, men ämnen som vi ofta berör är stress, mat, sömn, rörelse, tankar och beteenden. Dvs allt det som gör en mer eller mindre frisk och glad.
Utifrån dina behov så skapar vi en realistisk plan för hur du ska komma vidare och mot målet.
Vi delar gärna med oss av recept, meditationer, övningar, smarta lösningar och lifehacks, vill du ha någon sorts schema så kan vi göra det. Däremot så jobbar vi inte med kalorirestriktioner eller specifika dieter.
Rekommenderat 3-5 samtal, men det går självklart bra att bara göra ett samtal (eller jättemånga fler :)
Vi arbetar utifrån ett salutogent förhållningssätt och använder oss av MI metoden (motivational interviewing), vilket båda är erkända och evidensbaserade metoder med fina resultat.
Vårt mål är att du ska hitta ditt sätta att göra en förändring så att du kan leva det liv du vill leva!
Maria Troive Lindell är diplomerad MI samtalsterapeut. MI står för Motivational Interviewing och är en metod som går ut på att hjälpa klienten hitta sin egen styrka och motivation att göra en bestående förändring.
Om du har mer frågor om metoden, eller om hur samtalen går till, så hör gärna av dig till:
maria@cohealth.se
Pris890 kr
Hälsocoaching inledande lite längre samtal
75 min
Hälsocoaching
INLEDANDE SAMTAL
Hälsocoaching
En serie motiverande samtal för dig som vill öka din hälsa och välmående i ditt liv. En livsstilsförändring helt enkelt.
Tillsammans tittar vi på hur du lever idag, och vad det är som du skulle vilja förändra.
Du väljer fokus, men ämnen som vi ofta berör är stress, mat, sömn, rörelse, tankar och beteenden. Dvs allt det som gör en mer eller mindre frisk och glad.
Utifrån dina behov så skapar vi en realistisk plan för hur du ska komma vidare och mot målet.
Vi delar gärna med oss av recept, meditationer, övningar, smarta lösningar och lifehacks, vill du ha någon sorts schema så kan vi göra det. Däremot så jobbar vi inte med kalorirestriktioner eller specifika dieter.
Rekommenderat 3-5 samtal, men det går självklart bra att bara göra ett samtal (eller jättemånga fler :)
Vi arbetar utifrån ett salutogent förhållningssätt och använder oss av MI metoden (motivational interviewing), vilket båda är erkända och evidensbaserade metoder med fina resultat.
Vårt mål är att du ska hitta ditt sätta att göra en förändring så att du kan leva det liv du vill leva!
Maria Troive Lindell är diplomerad MI samtalsterapeut. MI står för Motivational Interviewing och är en metod som går ut på att hjälpa klienten hitta sin egen styrka och motivation att göra en bestående förändring.
Om du har mer frågor om metoden, eller om hur samtalen går till, så hör gärna av dig till:
maria@cohealth.se
Pris1 150 kr
Hälsocoaching serie av 3 samtal
60 min
Hälsocoaching
En serie motiverande samtal för dig som vill öka din hälsa och välmående i ditt liv. En livsstilsförändring helt enkelt.
Tillsammans tittar vi på hur du lever idag, och vad det är som du skulle vilja förändra.
Du väljer fokus, men ämnen som vi ofta berör är stress, mat, sömn, rörelse, tankar och beteenden. Dvs allt det som gör en mer eller mindre frisk och glad.
Utifrån dina behov så skapar vi en realistisk plan för hur du ska komma vidare och mot målet.
Vi delar gärna med oss av recept, meditationer, övningar, smarta lösningar och lifehacks, vill du ha någon sorts schema så kan vi göra det. Däremot så jobbar vi inte med kalorirestriktioner eller specifika dieter.
Rekommenderat 3-5 samtal, men det går självklart bra att bara göra ett samtal (eller jättemånga fler :)
Vi arbetar utifrån ett salutogent förhållningssätt och använder oss av MI metoden (motivational interviewing), vilket båda är erkända och evidensbaserade metoder med fina resultat.
Vårt mål är att du ska hitta ditt sätta att göra en förändring så att du kan leva det liv du vill leva!
Maria Troive Lindell är diplomerad MI samtalsterapeut. MI står för Motivational Interviewing och är en metod som går ut på att hjälpa klienten hitta sin egen styrka och motivation att göra en bestående förändring.
Om du har mer frågor om metoden, eller om hur samtalen går till, så hör gärna av dig till:
maria@cohealth.se
Pris2 100 kr
Hälsocoaching serie av 5 samtal
60 min
Hälsocoaching
En serie av 5 motiverande samtal för dig som vill öka din hälsa och välmående i ditt liv. En livsstilsförändring helt enkelt.
Tillsammans tittar vi på hur du lever idag, och vad det är som du skulle vilja förändra.
Du väljer fokus, men ämnen som vi ofta berör är stress, mat, sömn, rörelse, tankar och beteenden. Dvs allt det som gör en mer eller mindre frisk och glad.
Utifrån dina behov så skapar vi en realistisk plan för hur du ska komma vidare och mot målet.
Vi delar gärna med oss av recept, meditationer, övningar, smarta lösningar och lifehacks, vill du ha någon sorts schema så kan vi göra det. Däremot så jobbar vi inte med kalorirestriktioner eller specifika dieter.
Rekommenderat 3-5 samtal, men det går självklart bra att bara göra ett samtal (eller jättemånga fler :)
Vi arbetar utifrån ett salutogent förhållningssätt och använder oss av MI metoden (motivational interviewing), vilket båda är erkända och evidensbaserade metoder med fina resultat.
Vårt mål är att du ska hitta ditt sätta att göra en förändring så att du kan leva det liv du vill leva!
Maria Troive Lindell är diplomerad MI samtalsterapeut. MI står för Motivational Interviewing och är en metod som går ut på att hjälpa klienten hitta sin egen styrka och motivation att göra en bestående förändring.
Om du har mer frågor om metoden, eller om hur samtalen går till, så hör gärna av dig till:
maria@cohealth.se
Pris3 500 kr
KONSULTATION OCH HÄLSOANALYS
4
PROVA PÅ blodanalys 30 min
30 min
Provet utförs genom ett litet stick i fingret, och vi analyserar levande och torkat blod. Den här tjänsten är till för dig som vill:
-Prova på en blodanalys innan du bestämmer dig för ett längre nybesök.
-Göra regelbundna hälsokontroller, men inte behöver mer omfattande rådgivning.
OBS! Den är inte till för dig som vill:
-Ha råd om hur du ska förbättra din hälsa.
-Gå djupare och få en utförlig sammanfattning av ditt hälsotillstånd. (För dig rekommenderas tjänsten NYBESÖK)
Under blodanalysen tittar vi tillsammans på några droppar av ditt blod i mikroskop direkt på plats och du kan samtidigt följa med på en skärm.
Dessa tendenser kan vi se i blodet:
Hur aktivt immunförsvaret är.
Tecken på inflammation i kroppen.
Hur du påverkas av stress.
Brist på B12, folsyra och järn.
Matsmältningsproblem.
Belastad lever och / eller njurar.
Blodcirkulationsproblem.
Läckande tarm.
Candida (svamp) och bakterier.
Vårt blod har kontakt med nästan varenda cell i hela kroppen. Dess betydelse är livsavgörande för vår överlevnad, och att det fungerar felfritt är grundläggande för vårt välbefinnande. Blodets funktion är bl.a. att transportera syre, dvs hjälpa kroppen att andas. Men också att transportera näringsämnen och föra bort avfallsprodukter, samt bekämpa infektioner.
Konsultationen utförs av Maria Troive Lindell, diplomerad Hälsopedagog, Kost- och näringsterapeut samt motivationscoach.
Pris450 kr
Urinprov
15 min
Denna urinanalys undersöker:
Surhet eller pH = Om värdet är onormalt kan det vara ett tecken på problem i urinvägarna eller njurarna.
Densitet = En hög densitet är ett symptom på uttorkning.
Protein = Förhöjt protein är ett tecken på njurproblem.
Glukos = Om urinen innehåller glukos kan det vara ett tecken på diabetes.
Ketonkroppar = Indikerar också diabetes, särskilt dekompensationer som kan vara allvarliga.
Bilirubin = Dess närvaro antyder möjligheten till leversjukdom eller leverskada.
Blod = Detta kan vara ett tecken på infektion, njurskada, njursten eller njur- eller urinblåsecancer. Det är ett tecken som behöver kompletterande metoder för att komma fram till en diagnos.
Nitriter eller leukocytesteras = Förmodligen en infektion.
Urinprovet rekommederas att tas i samband med blodmikroskopering.
Ingår i tjänsten NYBESÖK.
Pris250 kr
HÄLSOKAMPANJ
45 min
Vi tittar på en droppe blod från ditt finger. Du får följa med på skärmen medan jag berättar vad jag ser i ditt blod.
Du får även besvara ett antal frågor utifrån vad vi sett i blodet samt vad du svarat, kan du få några tips på hur du kan förbättra din hälsa.
Pris500 kr
Allergitest 270 födoämnen
30 min
Allergitest tas på kliniken med hjälp av stick i fingret. Vi samarbetar med ett laboratorium i Tyskland som analyserar typ 3-allergier, som är när immunförsvaret reagerar på olika livsmedel. Detta leder till inflammation samt ev. smärta i kroppen och ett nedsatt skydd mot infektioner, virus och andra sjukdomar.
Testet finns i tre olika storlekar:
44 födoämnen för 1490 kr.
99 födoämnen för 2990 kr.
270 födoämnen inkl. candida för 4950 kr.
PrisGratis
KOST
4
Kostrådgivning Uppföljning 30 min
30 min
Detta är uppföljande samtal för dig som redan varit på minst en 60 min kostrådgivning hos oss.
För dig som behöver stöttning på vägen, har ytterligare frågor eller behov.
Pris350 kr
Motiverande kostsamtal 60 min
60 min
För dig som verkligen vill förändra din kost!
Coachande kostrådgivning som fokuserar inte bara på vad du ska äta, utan också hur och varför du äter som du gör just nu, hur du önskar att det var, och hur du ska komma dit. Tillsammans rör oss från ide till motivation till aktion och kommer fram till en kostplan som fungerar för dig.
För bäst resultat rekommenderar vi 3-5 samtal. Ibland behövs det mer, ibland mindre.
Vi jobbar inte med kalorirestriktion, dieter eller pekpinnar. Vårt motto är att det ska vara gott, enkelt och härligt att äta och ta hand om sig själv.
Pris890 kr
Motiverande kostsamtal x 3
60 min
För dig som verkligen vill förändra din kost!
Coachande kostrådgivning som fokuserar inte bara på vad du ska äta, utan också hur och varför du äter som du gör just nu, hur du önskar att det var, och hur du ska komma dit. Tillsammans rör oss från ide till motivation till aktion och kommer fram till en kostplan som fungerar för dig.
För bäst resultat rekommenderar vi 3-5 samtal.
Detta är en serie på 3 samtal a 60 min vid tre tillfällen.
Det går även bra att boka enstaka samtal, eller en serie på fem.
Vi jobbar inte med kalorirestriktion, dieter eller pekpinnar. Vårt motto är att det ska vara gott, enkelt och härligt att äta och ta hand om sig själv.
Pris2 100 kr
Motiverande kostsamtal x 5
60 min
För dig som verkligen vill förändra din kost!
Coachande kostrådgivning som fokuserar inte bara på vad du ska äta, utan också hur och varför du äter som du gör just nu, hur du önskar att det var, och hur du ska komma dit. Tillsammans rör oss från ide till motivation till aktion och kommer fram till en kostplan som fungerar för dig.
Detta är en serie på 5 samtal a 60 min, vid fem separata tillfällen.
Vi jobbar inte med kalorirestriktion, dieter eller pekpinnar. Vårt motto är att det ska vara gott, enkelt och härligt att äta och ta hand om sig själv.
Pris3 500 kr
MENTAL TRÄNING / PERSONLIGHETSUTVECKLING
3
NLP hypnos 3 ggr paketpris
90 min
Tre NLP hypnos behandlingar (90+60+60 min) till paketpriset 2650 kr (spara 500 kr). Boka den första tiden här, så hjälper vi dig att boka de två följande tiderna.
När du känner att du fastnat, kanske redan sökt förändring genom andra metoder, men inte kommit dit du vill. Då kan vägen ut vara hypnos, där vi använder oss av NLP-teknik.
NLP är ett mycket effektivt instrument för personlig utveckling och det är möjligt att uppnå bestående resultat på förvånansvärt kort tid.
Våra invanda mönster har skapat som en motorväg i hjärnan, som gör att signalerna väljer att ta samma snabba väg, och att vi därför i många lägen agerar eller reagerar per automatik.
För att ändra ett beteende, måste vi bygga nya vägar i hjärnan. Det bästa sättet att göra detta på, är i ett avslappnat tillstånd. Då vilar våra skyddsmekanismer, som annars skulle stoppa upp förändringsprocessen.
Behandlingen går till så här:
Vi börjar med ett inledande samtal om dig och det du vill förändra. Under djupavslappning tar vi sedan upp olika situationer, och kodar om hjärnan för att skapa nya tankar och mönster.
Normalt krävs det tre tillfällen för att bryta ett mönster.
Första gången ses vi i 1,5 timme. Vid andra och tredje tillfället tar det max en timme.
Om du har något av följande problem, så rekommenderar vi dig att prova NLP:
• Beroende (av t.ex socker, alkohol, cigaretter, skräpmat).
• Oönskat beteendemönster (t.ex. dåliga matvanor, komma försent, skjuta upp
saker, lathet, självdestruktivitet).
• Kronisk smärta eller psykiska problem.
• Rädsla eller fobi (t.ex förlossningsrädsla, flygrädsla, rädsla för att hålla tal,
höjdrädsla, spindelfobi, etc.).
• Svårighet att formulera mål (för att komma dit du vill i livet).
Behandlingen har visat sig effektiv på alla ovanstående problem. Oftast behöver man bara två-tre tillfällen för att lösa problemet. Detta gör metoden billigare än andra terapier, där man vanligtvis behöver gå många fler gånger för att bli av med sina besvär.
Pris2 700 kr
Hypnos (återkommande besök)
60 min
När du känner att du fastnat, kanske redan sökt förändring genom andra metoder, men inte kommit dit du vill. Då kan vägen ut vara hypnos, där vi använder oss av NLP-teknik.
NLP är ett mycket effektivt instrument för personlig utveckling och det är möjligt att uppnå bestående resultat på förvånansvärt kort tid.
Våra invanda mönster har skapat som en motorväg i hjärnan, som gör att signalerna väljer att ta samma snabba väg, och att vi därför i många lägen agerar eller reagerar per automatik.
För att ändra ett beteende, måste vi bygga nya vägar i hjärnan. Det bästa sättet att göra detta på, är i ett avslappnat tillstånd. Då vilar våra skyddsmekanismer, som annars skulle stoppa upp förändringsprocessen.
Behandlingen går till så här:
Vi börjar med ett inledande samtal om dig och det du vill förändra. Under djupavslappning tar vi sedan upp olika situationer, och kodar om hjärnan för att skapa nya tankar och mönster.
Normalt krävs det tre tillfällen för att bryta ett mönster.
Första gången ses vi i 1,5 timme. Vid andra och tredje tillfället tar det max en timme.
Om du har något av följande problem, så rekommenderar vi dig att prova NLP:
• Beroende (av t.ex socker, alkohol, cigaretter, skräpmat).
• Oönskat beteendemönster (t.ex. dåliga matvanor, komma försent, skjuta upp saker, lathet, självdestruktivitet).
• Kronisk smärta eller psykiska problem.
• Rädsla eller fobi (t.ex förlossningsrädsla, flygrädsla, rädsla för att hålla tal, höjdrädsla, spindelfobi, etc.).
• Svårighet att formulera mål (för att komma dit du vill i livet).
Behandlingen har visat sig effektiv på alla ovanstående problem. Oftast behöver man bara två-tre tillfällen för att lösa problemet. Detta gör metoden billigare än andra terapier, där man vanligtvis behöver gå många fler gånger för att åstadkomma en förändring.
Pris950 kr
Hypnos (första besöket)
90 min
När du känner att du fastnat, kanske redan sökt förändring genom andra metoder, men inte kommit dit du vill. Då kan vägen ut vara hypnos, där vi använder oss av NLP-teknik.
NLP är ett mycket effektivt instrument för personlig utveckling och det är möjligt att uppnå bestående resultat på förvånansvärt kort tid.
Våra invanda mönster har skapat som en motorväg i hjärnan, som gör att signalerna väljer att ta samma snabba väg, och att vi därför i många lägen agerar eller reagerar per automatik.
För att ändra ett beteende, måste vi bygga nya vägar i hjärnan. Det bästa sättet att göra detta på, är i ett avslappnat tillstånd. Då vilar våra skyddsmekanismer, som annars skulle stoppa upp förändringsprocessen.
Behandlingen går till så här:
Vi börjar med ett inledande samtal om dig och det du vill förändra. Under djupavslappning tar vi sedan upp olika situationer, och kodar om hjärnan för att skapa nya tankar och mönster.
Normalt krävs det tre tillfällen för att bryta ett mönster.
Första gången ses vi i 1,5 timme. Vid andra och tredje tillfället tar det max en timme.
Om du har något av följande problem, så rekommenderar vi dig att prova NLP:
• Beroende (av t.ex socker, alkohol, cigaretter, skräpmat).
• Oönskat beteendemönster (t.ex. dåliga matvanor, komma försent, skjuta upp
saker, lathet, självdestruktivitet).
• Kronisk smärta eller psykiska problem.
• Rädsla eller fobi (t.ex förlossningsrädsla, flygrädsla, rädsla för att hålla tal,
höjdrädsla, spindelfobi, etc.).
• Svårighet att formulera mål (för att komma dit du vill i livet).
Behandlingen har visat sig effektiv på alla ovanstående problem. Oftast behöver man bara två-tre tillfällen för att lösa problemet. Detta gör metoden billigare än andra terapier, där man vanligtvis behöver gå många fler gånger för att bli av med sina besvär.
Pris1 250 kr
ONLINE TJÄNSTER
1
ONLINE hälsorådgivning EXPRESS
30 min
Hälsorådgivning EXPRESS är för dig som behöver/måste hålla dig hemma och samtidigt vill få snabba, enkla, naturliga knep, tips och råd på vad du själv kan göra för att hålla dig frisk, minska på symptom eller kurera dig på egen hand.
Fokus i samtalet ligger på vad du kan göra här och nu för att öka din beredskap eller kurera dig inför influensa, förkylningar, virus, mm.
Råden grundas på beprövad erfarenhet, naturliga och holistiska metoder, vilket innebär att vi ser och tar hänsyn till hela dig, din omgivning och livssituation.
Du bestämmer vad vi ska prata om, men ofta handlar det om hur just du kan:
- Stärka och underlätta för ditt immunförsvar att ta hand om dig.
- Lugna oro och få ordning på tankarna.
- Komma igång med hälsosamma rutiner och vanor.
- Bli frisk snabbare eller minska på symtom.
Det går till så här:
1. Boka din tid här på Boka direkt.
2. Skriv i din bokning (under noteringar) hur du vill att vi kontaktar dig. Välj emellan:
-Telefon
-Zoom
-Skype
3. Lämna de uppgifter som krävs för att kontakta dig på det sätt du valt, dvs ditt telefonnummer, skypenamn eller Facebook namn.
4. Swisha din betalning till oss.
5. Vi kontaktar dig på den avtalade tiden.
Om du har några frågor, tveka inte att kontakta oss via mail eller telefon.
maria@cohealth.se 070 649 86 02
Pris350 kr
Omdömen
4.7av5
5









(85)
4









(29)
3









(2)
2









(0)
1









(1)
Sida 1 av 1
Om företaget
Vi erbjuder funktionsmedicin, coachning, kostrådgivning samt NLP hypnos (mental träning under djupavslappning).
Genom att se dig, din kropp och dina tankar som en helhet, har vi sedan möjlighet att angripa problemen från flera olika håll.
Vår inställning är att om vi hittar orsaken till dina symptom, finns det också en möjlighet att hjälpa dig. Därför behandlar vi inte enbart symptomen. Vi går djupare. Om du är nyfiken på hur ditt blod ser ut i mikroskopet, vill ta tag i onödiga eller plågsamma fysiska symptom, ändra dina tankar och beteendemönster, eller bara ha en skön massage, så är du varmt välkommen! Ring 070-6498602 så får du veta mer.
Ordinarie öppettider
- Måndag09:00 - 18:30
- Tisdag08:30 - 15:30
- Onsdag08:30 - 20:00
- Torsdag10:00 - 15:30
- Fredag08:30 - 15:30
- LördagStängt
- SöndagStängt
Kontakt
- 070-649 86 XX
Länkar
Adress
792 30, Mora

